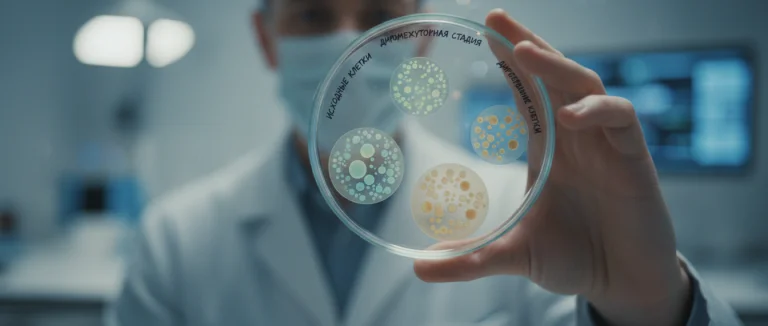
Дифференциация стволовых клеток

Диаграмма стволовых клеток: типы, дифференциация и терапия
-
Типы стволовых клеток и их характеристики
-
Как работает дифференциация: от плюрипотентных к специализированным
-
Терапия стволовыми клетками: клинические применения
-
Преимущества и риски терапии стволовыми клетками
-
Будущее стволовых клеток: исследования и инновации
-
Почему выбирают Лив Хоспитал
Диаграмма стволовых клеток служит наглядным инструментом для понимания того, как эти уникальные клетки способны превращаться в любые типы тканей организма. В статье мы разберём основные типы стволовых клеток, их процесс дифференциации, а также текущие и перспективные применения в медицине.
Для пациентов, рассматривающих терапию стволовыми клетками, важно знать, какие клетки задействованы, как они взаимодействуют с организмом и какие результаты можно ожидать. По данным международных исследований, более 70 % пациентов отмечают улучшение качества жизни после процедур, основанных на стволовых клетках.
Мы также расскажем, как в Лив Хоспитал используют современные методы, подкреплённые научными данными, чтобы обеспечить безопасные и эффективные лечения.
Типы стволовых клеток и их характеристики
Существует несколько основных категорий стволовых клеток, каждая из которых обладает своими особенностями и потенциалом для регенерации.
| Тип клетки | Источник | Потенциал дифференциации |
|---|---|---|
| Эмбриональные стволовые клетки | Эмбрионы ранней стадии | Плюрипотентные – могут стать любой клеткой тела |
| Гематопоэтические стволовые клетки | Костный мозг, периферическая кровь | Только клетки крови и иммунной системы |
| Мезенхимальные стволовые клетки | Костный мозг, жировая ткань | Мультипотентные – кости, хрящ, жировая ткань |
Эти типы часто изображаются на диаграмме стволовых клеток, где цветом выделяется степень их плюрипотентности. Плюрипотентные клетки находятся в центре схемы, а более специализированные – ближе к периферии.

Как работает дифференциация: от плюрипотентных к специализированным
Дифференциация – процесс, при котором стволовые клетки превращаются в специализированные клетки, такие как нейроны, кардиомиоциты или эпителиальные клетки. На диаграмме стволовых клеток этот процесс часто изображается в виде ветвящегося дерева.
Этапы дифференциации
- Инициация – активация генов, отвечающих за развитие конкретной линии.
- Пролиферация – увеличение количества предшественников.
- Специализация – окончательное формирование функции клетки.
В лабораторных условиях учёные используют факторы роста, химические сигналы и биосовместимые матрицы, чтобы направлять клетки по нужному пути. Такие методики позволяют получать клетки для лечения заболеваний сердца, позвоночника и даже диабета.
Терапия стволовыми клетками: клинические применения
Терапия стволовыми клетками уже применяется в ряде областей медицины, демонстрируя значительные результаты. На диаграмме стволовых клеток часто выделяют зоны применения, такие как ортопедия, кардиология и неврология.
Основные направления лечения
- Регенерация хрящевой ткани при остеоартрите.
- Восстановление миокарда после инфаркта.
- Лечение спинальных травм и дегенеративных заболеваний нервной системы.
- Поддержка при онкологических заболеваниях (трансплантация гемопоэтических стволовых клеток).
| Заболевание | Тип клетки | Результат терапии |
|---|---|---|
| Остеоартрит | Мезенхимальные стволовые клетки | Уменьшение боли, восстановление хряща |
| Ишемический инсульт | Мезенхимальные стволовые клетки | Снижение объёма инфаркта, улучшение функций |
| Лейкемия | Гематопоэтические стволовые клетки | Полное ремиссионное состояние |
Лив Хоспитал предлагает индивидуальные программы, включающие подготовку пациента, проведение процедуры и последующее наблюдение, что повышает эффективность лечения.

Преимущества и риски терапии стволовыми клетками
Как и любая медицинская процедура, лечение стволовыми клетками имеет свои плюсы и потенциальные осложнения. На диаграмме стволовых клеток часто изображают баланс между этими факторами.
Преимущества
- Минимальная инвазивность по сравнению с традиционной хирургией.
- Способность восстанавливать повреждённые ткани без риска отторжения.
- Гибкость в выборе типа клетки под конкретную задачу.
Риски
- Возможность нежелательной дифференциации и образования опухолей.
- Иммунные реакции при использовании донорских клеток.
- Неоднозначные результаты при неподходящем протоколе.
В Лив Хоспитал каждый случай тщательно оценивается, а протоколы лечения соответствуют международным стандартам JCI, что снижает вероятность осложнений.
Будущее стволовых клеток: исследования и инновации
Научные исследования продолжают расширять границы возможностей стволовых клеток. Современные проекты включают генетическое редактирование, создание органоидов и 3‑D биопечать тканей.
Ключевые направления
- CRISPR‑терапия в сочетании со стволовыми клетками для коррекции генетических заболеваний.
- Развитие «органоидных» моделей для тестирования лекарств без животных.
- Биопечать органов из пациента‑специфических стволовых клеток.
Эти инновации уже находят отражение в новых схемах диаграммы стволовых клеток, где добавляются новые ветви, указывающие на будущие возможности. Лив Хоспитал активно участвует в международных клинических исследованиях, предлагая пациентам доступ к передовым методикам.
Почему выбирают Лив Хоспитал
Лив Хоспитал — аккредитованная JCI группа частных больниц в Стамбуле, специализирующаяся на международных пациентах. Мы предоставляем комплексный сервис: от записи на приём и организации трансфера до профессионального переводчика и помощи с размещением. Наши программы терапии стволовыми клетками основаны на последних научных данных и соблюдают строгие стандарты безопасности.
Готовы узнать, как терапия стволовыми клетками может изменить вашу жизнь? Свяжитесь с нашими специалистами уже сегодня и получите персональную консультацию.
Позвоните или оставьте заявку, и мы поможем подобрать оптимальный план лечения, учитывая ваши индивидуальные потребности.
Часто задаваемые вопросы
Дифференциация стволовых клеток – это последовательный набор биохимических и генетических событий, при которых клетки меняют свою морфологию и функции, становясь, например, нейронами, кардиомиоцитами или эпителиальными клетками. В лаборатории процесс регулируется факторами роста, химическими сигналами и биосовместимыми матрицами. Правильное управление дифференциацией позволяет получать клетки для лечения сердечных заболеваний, травм спинного мозга и даже диабета.
Эмбриональные стволовые клетки обладают плюрипотентностью и могут стать любой клеткой организма, однако их использование ограничено этическими вопросами. Гемопоэтические клетки берутся из костного мозга или периферической крови и применяются при лечении лейкемии и других заболеваний крови. Мезенхимальные клетки, получаемые из костного мозга или жировой ткани, широко используют для регенерации хрящевой ткани, восстановления миокарда и лечения неврологических травм.
В Лив Хоспитал предлагают индивидуальные программы, включающие подготовку пациента, инфузию мезенхимальных или гемопоэтических стволовых клеток и последующее наблюдение. При остеоартрите клетки способствуют восстановлению хряща и уменьшению боли. При инсульте они снижают объём поражения и восстанавливают функции. При лейкемии используется трансплантация гемопоэтических клеток, обеспечивая полную ремиссию. При инфаркте миокарда мезенхимальные клетки помогают восстановить повреждённые участки сердца.
Как и любая медицинская процедура, терапия стволовыми клетками имеет потенциальные осложнения. Неправильный протокол может привести к образованию кисты или опухолей из-за неконтролируемой дифференциации. При использовании донорских клеток возможны иммунные реакции и отторжение. Поэтому в Лив Хоспитал каждый случай проходит строгую оценку, а протоколы соответствуют международным стандартам JCI, что минимизирует вероятность осложнений.
Будущее стволовых клеток связано с интеграцией технологий CRISPR для коррекции генетических заболеваний, созданием органоидных моделей, позволяющих тестировать лекарства без животных, и 3‑D биопечатью тканей и органов, полностью совместимых с пациентом. Эти направления уже отражаются в новых схемах диаграмм стволовых клеток, где добавляются ветви, указывающие на генетическую терапию, органоидные исследования и биопечатные органы. Лив Хоспитал активно участвует в международных клинических исследованиях, предоставляя пациентам доступ к передовым методикам.
Лив Хоспитал – это сеть частных больниц в Стамбуле, аккредитованная международным стандартом JCI. Больница предлагает комплексный сервис для международных пациентов: помощь с трансфером, переводчиками, размещением и полным сопровождением лечения. Программы терапии стволовыми клетками основаны на последних научных данных, проходят строгий контроль качества и соответствуют мировым клиническим протоколам, что обеспечивает высокую эффективность и безопасность процедур.
* Содержимое нашего сайта предназначено только для информационных целей. Обязательно обратитесь к врачу для диагностики и лечения. В содержание страницы не включены элементы, содержащие информацию о терапевтических медицинских услугах в Лив Госпитале.












